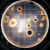

[an error occurred while processing this directive]

Fotografía industrial y foto para catalogos
Realizada en locación de la ciudad de Querétaro
Reportaje gráfico comercial
Contiene 10 imágenes
Reportaje simple
Contiene 3 imágenes
Si se desean imágenes adicionales se solicitan por separado con un costo adicional cada una.
Estas imágenes se entregan con los derechos para uso comercial no exclusivo. Si se requiere una licencia diferente deberá ser presupuestada.
Estos precios no incluyen IVA. Cualquier trabajo requiere un 50% de anticipo.
Fotografía industrial
Como fotógrafo profesional en industria, Héctor Hernández logra que los clientes actuales y futuros puedan conocer más de cada empresa y sus productos, y se lleven una excelente imagen de ellos. En el estudio fotográfico cuidamos que esta imagen transmita claramente lo que se quiere comunicar y que además impacte al público al cual se pretende llegar.
Obtenga fotos profesionales de cualquier giro industrial que reflejen lo mejor de su empresa o su fotografía de producto. La imagen de su compañía es muy importante, logramos captar las mejores perspectivas de su empresa con fotos panorámicas, de su personal o de las instalaciones.
Tenemos también paquetes para sesiones fotográficas publicitarias para anuncios en revistas, posters y más. La fotografía publicitaria es una inversión valiosa para las empresas.
Atiende Distrito Federal, Querétaro, Toluca y resto de México.